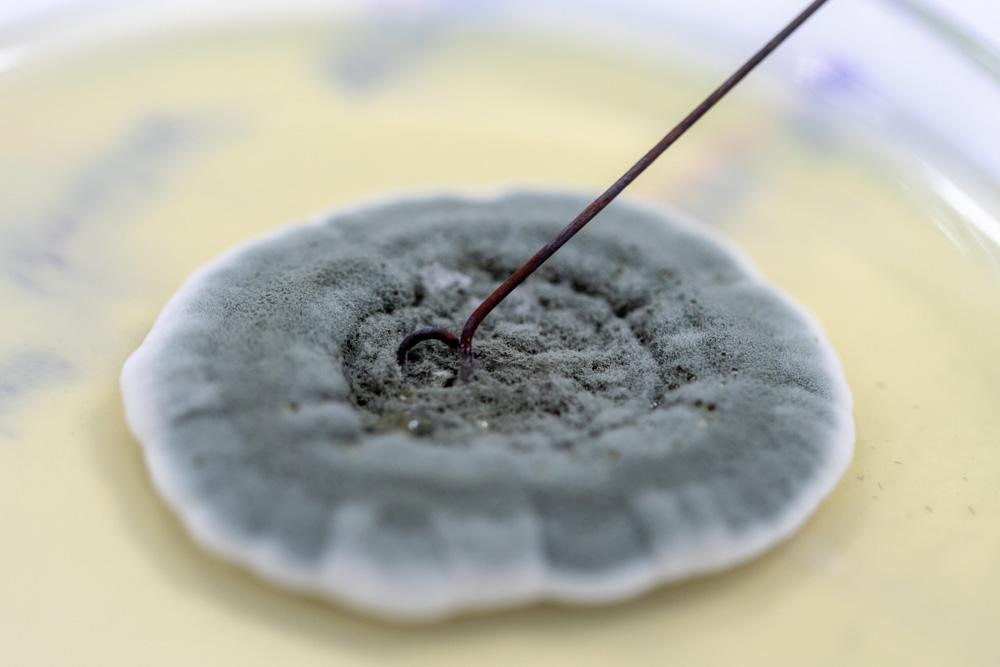

Fully Certified And Licensed
Operating Since 2011
Mold Inspection
Indoor Air Quality (IAQ)
Mycotoxins
VOC | Formaldehyde
Radon
Lead Paint Inspection

Mycotoxins
ERMI HERTSMI-2

CIRS Chronic Inflammatory Response Syndrome

Environmentally Sensitized Individuals

Data Driven Evidence Based Assessments
Client Reviews
Great experience with mr. Scheyer in South Plainfield, NJ. He is a consummate professional who really cares about his work, the property in question, and the client. He was thorough and took the time to really explain everything. He did not upsell and the prices were very reasonable. Great work, and fast turn-around for testing results. 10/10 Would work with him again. Thank you!
read moreread less
Henry did an amazing job inspecting our house. He not only gave us reassurance about the areas that need mold remediation, but also provided a clear, big-picture understanding of how our home is doing overall. He explained what should be addressed now and what we can do in the future to keep the house safe, healthy, and efficient. We truly appreciate his thoroughness, attention to detail, and the time he took to answer all of our questions. Highly recommend!
read moreread less
A true professional! Look no further for a knowledgeable, thoughtful, detail-oriented specialist in his field. Henry truly takes his time with his customers and knows what he is talking about when it comes to air quality, HVAC systems, etc. I can’t recommend him enough!
read moreread less
We had a fantastic experience with Henry from Mold Testing NJ-NY. He recently performed a post-remediation inspection at our home in Elmwood Park and was incredibly thorough, knowledgeable, and professional throughout the entire process.
Henry took the time to explain everything clearly, from how the air and surface samples work to what the results meant for our family's health and safety. He identified a few minor areas that still needed attention and provided straightforward, actionable recommendations to make sure the remediation was fully complete.
We really appreciated his honesty, attention to detail, and the peace of mind his inspection gave us. If you're in need of mold testing or indoor air quality assessments in the Elmwood Park area (or anywhere nearby), we highly recommend Henry!
Henry took the time to explain everything clearly, from how the air and surface samples work to what the results meant for our family's health and safety. He identified a few minor areas that still needed attention and provided straightforward, actionable recommendations to make sure the remediation was fully complete.
We really appreciated his honesty, attention to detail, and the peace of mind his inspection gave us. If you're in need of mold testing or indoor air quality assessments in the Elmwood Park area (or anywhere nearby), we highly recommend Henry!
read moreread less
We used Henry after our home inspection in Saddle River turned up suspicion for mold. He was prompt to respond and was able to get out to us quickly to test. He was thorough and very knowledgeable. We will use him again and I would recommend him to anyone for testing.
read moreread less
Henry is an exceptional mold inspector who has assisted me with two different houses, both of which had mold issues in their basements. His thoroughness is unmatched; he meticulously inspected every corner of the affected areas, ensuring that no mold was left undiscovered. Henry's honesty and transparency set him apart, as he provides straightforward assessment. He has a unique ability to explain complex mold issues in a way that is easy to understand, which is incredibly valuable to any homeowner.
What I appreciate most about Henry is his willingness and availability to answer as many questions as I had, no matter how detailed or numerous. He is patient and dedicated to educating his clients. In both cases, his expert advice and solutions were instrumental.
I highly recommend Henry to anyone in need of a mold inspection. Simply put, he's the best in the business.
What I appreciate most about Henry is his willingness and availability to answer as many questions as I had, no matter how detailed or numerous. He is patient and dedicated to educating his clients. In both cases, his expert advice and solutions were instrumental.
I highly recommend Henry to anyone in need of a mold inspection. Simply put, he's the best in the business.
read moreread less
Henry was right on time. set the the equipment up and started the testing. the test was complete inside and out. the written report was 30 pages and left no stone unturned Professional, knowledgeable, courteous is to say the least. Thanks Henry, we cant say enough nice things about you . We highly recommend Mold Testing NJ-NY!
read moreread less
I’m an asthmatic buying a home in Union Township for the first time, so I opted to test for mold. Henry was an absolute professional. From the moment we started speaking, he put me at ease with the process. He checked every inch of the house, and explained anything and everything that could be a concern. He answered all questions about what remediation may possibly look like depending on what results show, and most vitally, he explained that it was a conflict of interest for someone who does remediation to also test. For this reason I knew to stand firm on re-testing after remediation to ensure I was moving into a mold free home. For all your mold testing needs, please use Mold Testing NJ-NY.
read moreread less
Henry was beyond professional and extremely knowledgeable mold tester for our purchase of a home in Sparta, NJ. His report is detailed and is always happy to answer questions. He was always communicative during the inspection showing issues of mold. I would recommend anyone to use NJ-NY Mold Testing.
read moreread less
Mold Testing NJ-NY located in Mahwah did a great job for me. Henry really cares about finding the problem and retesting after remediation to ensure your home passes the air sample testing. All the remediators that I interviewed raved about Henry’s attention to detail. Thanks to Henry and the remediator I just received word that my home passed the final testing. Henry got the job done and is great to work with.
read moreread less
Henry was fantastic. We have lots of things that will need attention for our Oradell, NJ home in the near future and Henry provided so much valuable information. He offered lots of great recommendations on where to start and followed up with more the same day. He was on time, professional, and incredibly thorough. Most notably, very honest with his services and our needs; not trying to sell us on more than what he felt was necessary at this time. We’re hoping to not need his services again (moisture be gone!), but I would 100% recommend his services to family and friends.
read moreread less
How Do We Test For Mold?
Mold Testing NJ-NY enables the property owner to determine whether mold is present in the home or building, and if so, what type exists. Thorough testing is important to first determine if mold exists before any remediation is ever considered. It is ALSO important after remediation to ensure that mold has been fully eradicated.













